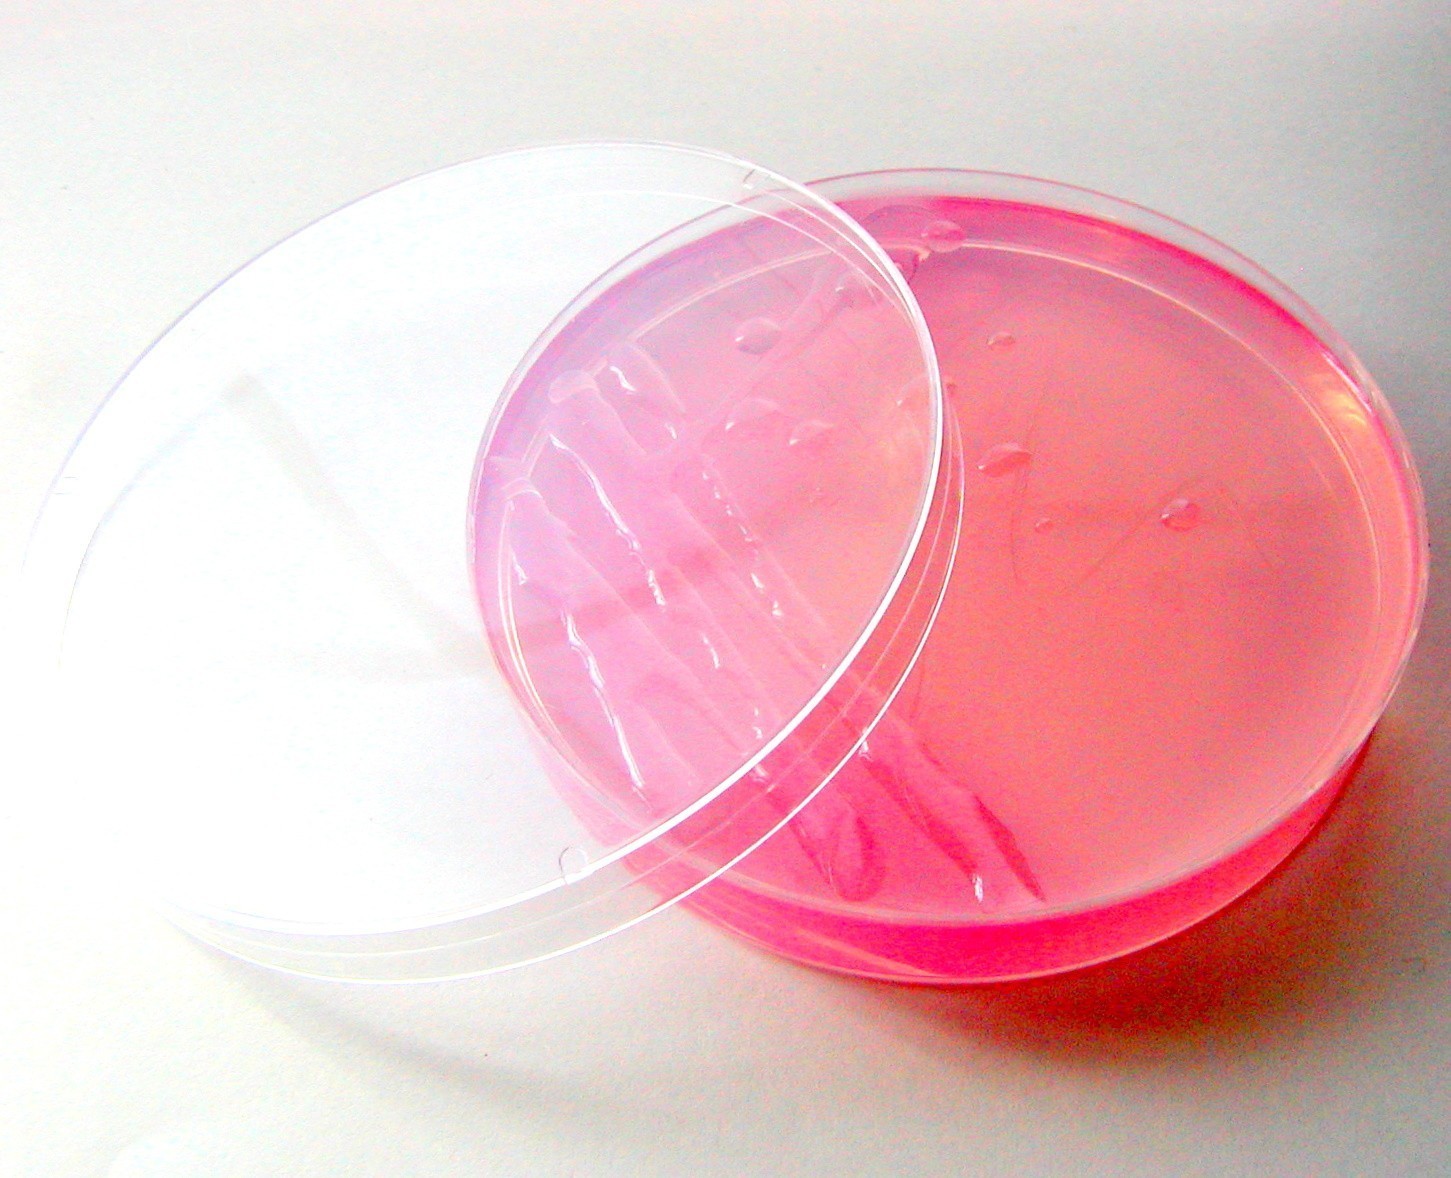

Фотографии исследований на чашках Петри Сабуро

Раздел: Природная галерея